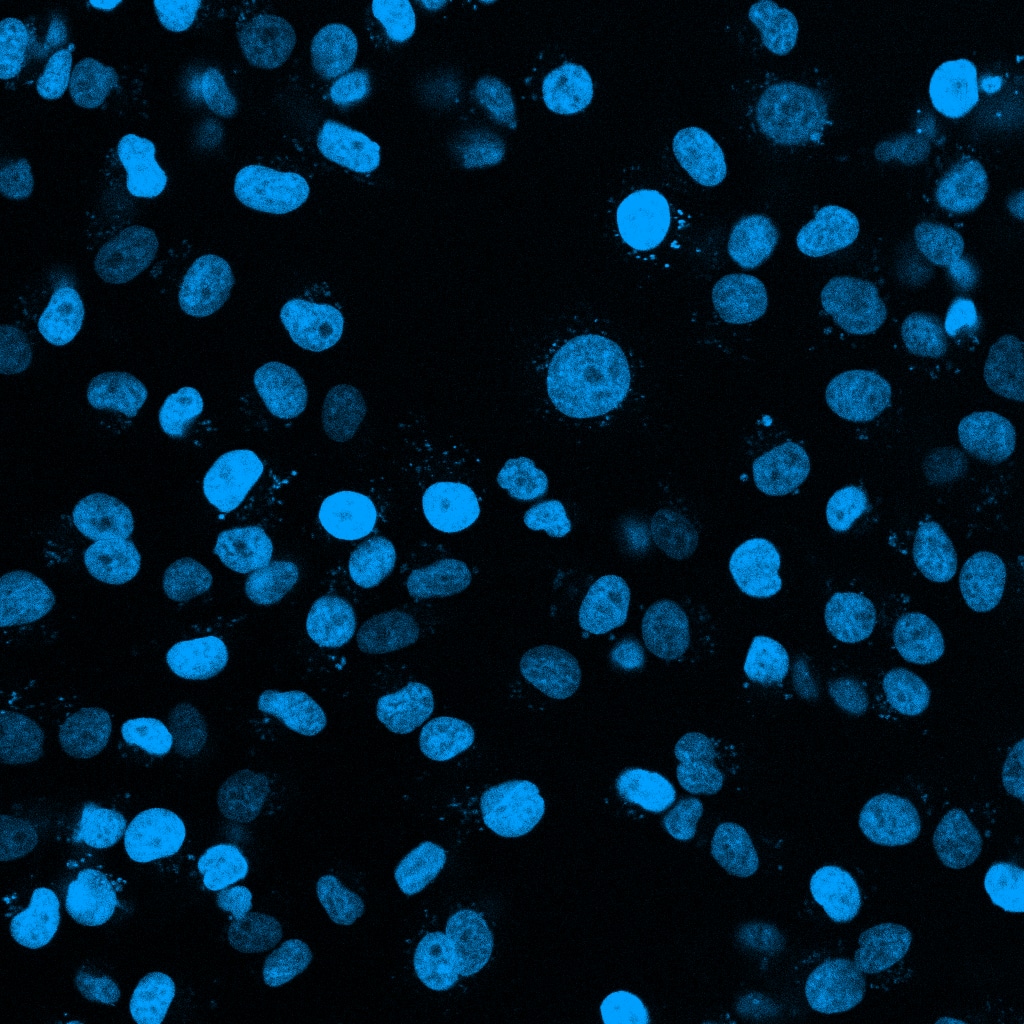

Submit a Review & Earn an Amazon Gift Card
You can now submit reviews for your favorite Tocris products. Your review will help other researchers decide on the best products for their research. Why not submit a review today?!
Submit ReviewNucleoLIVE™ Blue Non-Toxic Dye is a ready-to-use fluorescent probe for long term high content nuclear imaging in live cells. NucleoLIVE™ Blue, is the same as the original NucleoLIVE™ Non-Toxic Dye (Red), but with different spectral properties, allowing compatibility with ChromaLIVE™ Non-Toxic Dye (Cat. No.8934). Ideal for long term 2D and 3D cell organoids high-content imaging and real-time cell viability assays. NucleoLIVE™ Blue Non-Toxic Dye facilitates cell counting to accurately quantify cell toxicity, viability, and morphology by fluorescence on the blue channel, and can be used to generate growth curves to quantify drug effects on cell proliferation in real time and over multiple days. Allow wash-free imaging. NucleoLIVE™ Blue Non-Toxic Dye is provided as 50 µL of 1000x concentrate in DMSO.
Please refer to this protocol for further information on how to use this product.
NucleoLIVE™ is a trademark of Saguaro Biosciences.
View Larger
View Larger
NucleoLIVE™ Blue Non-Toxic Dye Phenotypic Imaging. MCF-7 cells stained with NucleoLIVE™ Blue Non-Toxic Dye to visualize nuclei and facilitate cell counting to accurately quantify cell proliferation in real time.
Sold under license from Saguaro Biosciences
Use our spectra viewer to interactively plan your experiments, assessing multiplexing options. View the excitation and emission spectra for our fluorescent dye range and other commonly used dyes.
Spectral Viewer| Storage | Store at -20°C |
| Purity | ≥90% (HPLC) |
The technical data provided above is for guidance only. For batch specific data refer to the Certificate of Analysis.
Tocris products are intended for laboratory research use only, unless stated otherwise.
| Solubility | Soluble in DMSO (supplied pre-dissolved in DMSO, 1000x) |
References are publications that support the biological activity of the product.
If you know of a relevant reference for NucleoLIVE™ Blue Non-Toxic Dye, please let us know.
Keywords: NucleoLIVE™ Blue Non-Toxic Dye, NucleoLIVE™ Blue Non-Toxic Dye supplier, Nucleolive, blue, non, toxic, dye, nuclear, stain, live, cell, imaging, fluorescence, fluorescent, 3D, culture, organoid, wash, free, toxicity, viability, assay, ready-to-use, high-content, no-wash, solution, Phenotypic, probe, Live-cell, Imaging, Other, Fluorescent, Dyes, 9011, Tocris Bioscience
Citations are publications that use Tocris products.
Currently there are no citations for NucleoLIVE™ Blue Non-Toxic Dye. Do you know of a great paper that uses NucleoLIVE™ Blue Non-Toxic Dye from Tocris? Please let us know.
There are currently no reviews for this product. Be the first to review NucleoLIVE™ Blue Non-Toxic Dye and earn rewards!
$25/€18/£15/$25CAN/¥75 Yuan/¥2500 Yen for a review with an image
$10/€7/£6/$10 CAD/¥70 Yuan/¥1110 Yen for a review without an image